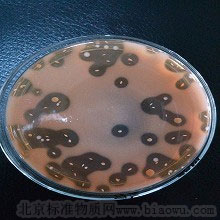
产品封面图

万千商家帮你免费找货
0 人在求购买到急需产品
- 详细信息
- 技术资料
- 英文名:
Virgibacillus pantothenticus
- 保质期:
1-2年
- 供应商:
北纳创联
| 基本信息 | |
| 资源编号 | BNCC212087 |
| 其它编号 | CGMCC1.2015 |
| 资源名称 | 泛酸枝芽孢菌 |
| 种属 | Virgibacillus pantothenticus |
| 提供形式 | 斜面培养物 |
| 安全等级 | 1 |
| 模式菌株 | no |
| 培养方法 | |
| 培养基 | CM0002 |
| 生长条件 | 28C |
| 存储条件 | 真空冷冻干燥 |
| 详细说明 | |
| 描述 | 菌落呈圆形,米黄色不透明,表面膜状,干燥,边缘不规则,无光泽,无晕环,中等,扁平。 |
风险提示:丁香通仅作为第三方平台,为商家信息发布提供平台空间。用户咨询产品时请注意保护个人信息及财产安全,合理判断,谨慎选购商品,商家和用户对交易行为负责。对于医疗器械类产品,请先查证核实企业经营资质和医疗器械产品注册证情况。
技术资料暂无技术资料 索取技术资料
北纳创联泛酸枝芽孢菌
询价